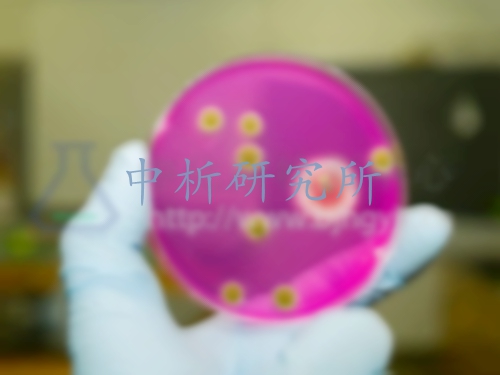

動物樣品檢測
1對1客服專屬服務,免費制定檢測方案,15分鐘極速響應
發布時間:2025-07-25 08:49:03 更新時間:2025-08-28 10:07:56
點擊:245
作者:中科光析科學技術研究所檢測中心

1對1客服專屬服務,免費制定檢測方案,15分鐘極速響應
發布時間:2025-07-25 08:49:03 更新時間:2025-08-28 10:07:56
點擊:245
作者:中科光析科學技術研究所檢測中心

動物樣品檢測去哪里做?中析研究所檢測中心可對各類動物樣品檢測,出具第三方動物樣品檢測報告。
腎臟:只考慮損傷,檢測肌酐,尿素氮,
血液:生長激素,類胰島素生長因子IGF-1,腫瘤壞死因子,堿性磷酸酶,酸性磷酸酶,谷丙轉氨酶,谷草轉氨酶
肝臟:谷丙轉氨酶,谷草轉氨酶
肝臟研磨液:丙二醛,AOC過氧化氫酶,谷胱甘肽過氧化物酶,SOD
1:認可,國際互認,報告廣泛采信
2:萬家合作企業,檢測測試經驗豐富,認證有效性強
3:全國多家分支機構,提供就近快速節省優質的服務
4:一站式服務能力(整合分析、檢測、工業診斷領域一站式服務,節省時間降低成本)
5:客戶滿意度高,充分體現了中析檢測服務帶給客戶的貢獻
1、在產品銷售或采購時,幫助交易雙方增進信任,促進成交;
2、在工程或項目投標時,證明產品質量;
3、在爭議仲裁,通過技術判斷協助區分各方責任;
4、在工藝改進或科研時,利用數據分析,查找問題根源。

證書編號:241520345370

證書編號:CNAS L22006

證書編號:ISO9001-2024001















版權所有:北京中科光析科學技術研究所京ICP備15067471號-33免責聲明